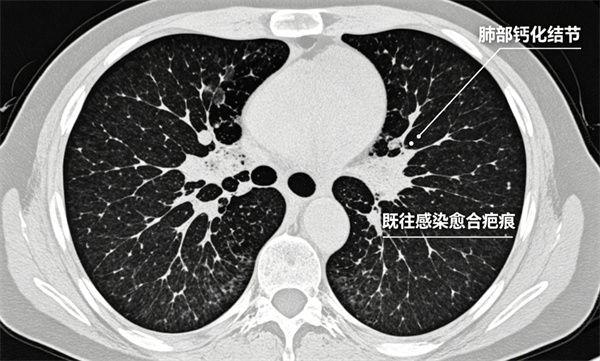
微信图片_2026-04-30_150720_214.jpg
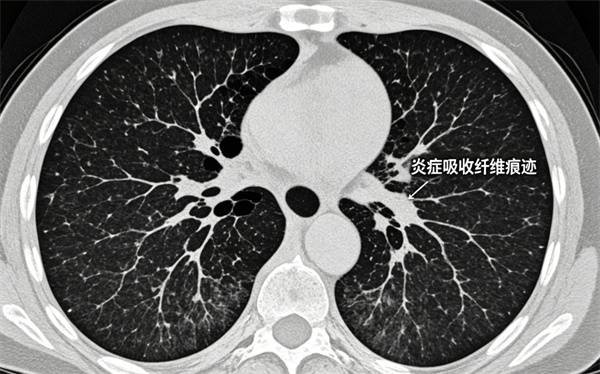
微信图片_2026-04-30_150725_890.jpg

桓兴科普丨一文教你轻松读懂肺部CT报告
拿到肺部CT报告,看着“结节、磨玻璃、条索影、胸膜增厚”等专业词汇,是不是瞬间紧张?担心是不是大病?害怕是不是肿瘤?
为帮助大家科学读懂报告、消除不必要焦虑,这篇文章为您带来详细的肺部CT报告解读,关键信息一看就懂!
看报告先抓重点:只看这一部分就够了
一份完整的肺部CT报告,分为影像描述和诊断意见两部分。
影像描述:医生对肺部影像的客观记录
诊断意见:医生给出的最终结论和建议
不必逐字逐句抠描述,更不要对着文字自行百度、过度解读,以每段文字的“建议、考虑、倾向、警惕”等诊断性词语或报告末尾的诊断意见为准。
报告高频术语,一次讲明白
*注:以下图片由AI生成
1肺结节
肺部直径<3cm的小病灶,统称为肺结节。

绝大多数为良性:炎症、淋巴结、陈旧病灶、肺泡增生等;
仅极少数需要重点关注;
风险高低看:大小、形态、密度、变化趋势。
肺结节 ≠ 肺癌,不必过度恐慌。

2磨玻璃结节 磨玻璃影
听到“磨玻璃”不必紧张,它不是癌的代名词。
常见原因:炎症、感染、出血、局部增生,也可见于早期肿瘤。
医生会结合多项指标综合判断,遵医嘱随访最重要。
3钙化结节
多为既往感染愈合后留下的疤痕,类似皮肤痘印。
几乎都是良性,一般无需治疗、无需复查。
4条索影 斑片影
肺部炎症吸收后留下的纤维痕迹,属于良性陈旧性改变。
无不适症状者,通常不影响健康。

5胸膜增厚
多由既往胸膜炎、肺部感染引起。
多数人无症状、无需处理。

6肺气肿 肺大泡
常见于长期吸烟、慢性咳嗽人群,属于肺部结构改变。
建议结合肺功能检查,在专科医生指导下管理。
查出肺结节,该怎么办?
<5mm:低危结节,年度复查即可 ;
5–8mm:遵医嘱定期随访观察;
>8mm 或形态不规则、分叶、毛刺:进一步专科评估。
不恐慌、不忽视、规范随访,是对待肺结节最科学的方式。
出现这些情况,请及时就医
1. 报告提示占位性病变、分叶、毛刺、胸膜牵拉;
2. 结节较前明显增大、密度增高;
3. 伴随痰中带血、胸痛、刺激性干咳、体重下降等症状。
温馨提示
1. 肺部CT是筛查早期肺病最有效的手段;
2. 报告中绝大多数描述为良性或陈旧性改变;
3. 不自行诊断、不盲目用药、不拖延复查;
4. 携带胶片和报告,前往呼吸科、胸外科、影像科就诊最稳妥。
健康无小事,早筛查、早发现、早干预,才是守护自己和家人最好的方式。
下一篇: 桓兴科普丨妇科手术科普













 京公网安备 11010502042000号
京公网安备 11010502042000号








